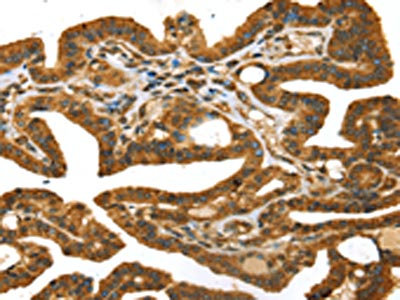

-
中文名稱:STX11兔多克隆抗體
-
貨號:CSB-PA022994
-
規格:¥1100
-
圖片:
-
The image on the left is immunohistochemistry of paraffin-embedded Human thyroid cancer tissue using CSB-PA022994(STX11 Antibody) at dilution 1/30, on the right is treated with fusion protein. (Original magnification: ×200)
-
Gel: 8%SDS-PAGE, Lysate: 40 μg, Lane: Mouse lung tissue, Primary antibody: CSB-PA022994(STX11 Antibody) at dilution 1/400, Secondary antibody: Goat anti rabbit IgG at 1/8000 dilution, Exposure time: 20 seconds
-
-
其他:
產品詳情
-
Uniprot No.:
-
基因名:STX11
-
別名:FHL4 antibody; HLH4 antibody; HPLH4 antibody; Stx11 antibody; STX11_HUMAN antibody; Syntaxin 11 antibody; Syntaxin-11 antibody
-
宿主:Rabbit
-
反應種屬:Human,Mouse
-
免疫原:Fusion protein of Human STX11
-
免疫原種屬:Homo sapiens (Human)
-
標記方式:Non-conjugated
-
抗體亞型:IgG
-
純化方式:Antigen affinity purification
-
濃度:It differs from different batches. Please contact us to confirm it.
-
保存緩沖液:-20°C, pH7.4 PBS, 0.05% NaN3, 40% Glycerol
-
產品提供形式:Liquid
-
應用范圍:ELISA,WB,IHC
-
推薦稀釋比:
Application Recommended Dilution ELISA 1:2000-1:5000 WB 1:500-1:2000 IHC 1:25-1:100 -
Protocols:
-
儲存條件:Upon receipt, store at -20°C or -80°C. Avoid repeated freeze.
-
貨期:Basically, we can dispatch the products out in 1-3 working days after receiving your orders. Delivery time maybe differs from different purchasing way or location, please kindly consult your local distributors for specific delivery time.
-
用途:For Research Use Only. Not for use in diagnostic or therapeutic procedures.
相關產品
靶點詳情
-
功能:SNARE that acts to regulate protein transport between late endosomes and the trans-Golgi network.
-
基因功能參考文獻:
- Neonatal platelets exhibit low levels of the Stx11-Munc18b complex (essential component of the SNARE machinery) and of beta1-tubulin. These developmental deficiencies are associated with defects in platelet adhesion, spreading and secretion. PMID: 29044293
- The results suggest that STX11 plays an important role in the pathogenesis of Peripheral T-cell lymphomas and they may contribute to the future development of new drugs for the treatment of Peripheral T-cell lymphomas. PMID: 26176172
- a pivotal role for S-acylation in the function of syntaxin 11 in NK cells PMID: 24910990
- Stx11 functions as a t-SNARE for the final fusion of LG at the IS. PMID: 24227526
- Distinct severity of HLH in both human and murine mutants with complete loss of cytotoxic effector PRF1, RAB27A, and STX11. PMID: 23160464
- These data indicate that human neutrophils express syntaxin 11 and call attention to the possible involvement of neutrophils in familial hemophagocytic lymphohistiocytosis pathology PMID: 19259622
- Platelets deficient in syntaxin-11 from a Familial Hemophagocytic Lymphohistiocytosis type 4 had secretion defect. PMID: 22767500
- Data suggest that syntaxin 11 promotes the fusion of Rab27a-expressing vesicles with cytotoxic granules and reveal additional complexity in spatial/temporal segregation of subcellular structures involved in granule-mediated cytotoxicity. PMID: 21342435
- No detrimental mutations were identified in STX11 in Chinese children with Epstein-Barr virus-associated hemophagocytic lymphohistiocytosis. PMID: 21674762
- STX11 should be sequenced in HLH patients even when impaired NK cell degranulation is not found PMID: 21298754
- a novel homozygous deletion (c. 581_584delTGCC; p.Leu194ProfsX2) in the gene-encoding syntaxin 11 (STX11), causing a premature termination codon in hemophagocytic lymphohistiocytosis PMID: 19967551
- The mutations in STX11 are responsible for HLH in approximately 1% of North American patients and can cause variable defects in syntaxin 11 expression and function with resultant impact on clinical phenotype. PMID: 20486178
- A large group of 63 unrelated patients with Familial hemophagocytic lymphohistiocytosis (FHL) was analysed for mutations in STX11, PRF1, and UNC13D. PMID: 16278825
- Defective cytotoxic lymphocyte degranulation is associated with syntaxin-11 deficient familial hemophagocytic lymphohistiocytosis 4 patients PMID: 17525286
- Syntaxin 11 plays a role in natural killer (NK) cell granule exocytosis and in the generation of cell-mediated killing. PMID: 17785771
- DNA methylation of Stx11 contribute to disease susceptibility at the 6q24 locus in humans. PMID: 19169743
- Familial hemophagocytic lymphohistiocytosis type 5 (FHL-5) is caused by mutations in Munc18-2 and impaired binding to syntaxin 11 PMID: 19804848
顯示更多
收起更多
-
相關疾病:Familial hemophagocytic lymphohistiocytosis 4 (FHL4)
-
亞細胞定位:Membrane; Peripheral membrane protein. Golgi apparatus, trans-Golgi network membrane; Peripheral membrane protein.
-
蛋白家族:Syntaxin family
-
數據庫鏈接:
Most popular with customers
-
-
YWHAB Recombinant Monoclonal Antibody
Applications: ELISA, WB, IHC, IF, FC
Species Reactivity: Human, Mouse, Rat
-
Phospho-YAP1 (S127) Recombinant Monoclonal Antibody
Applications: ELISA, WB, IHC
Species Reactivity: Human
-
-
-
-
-